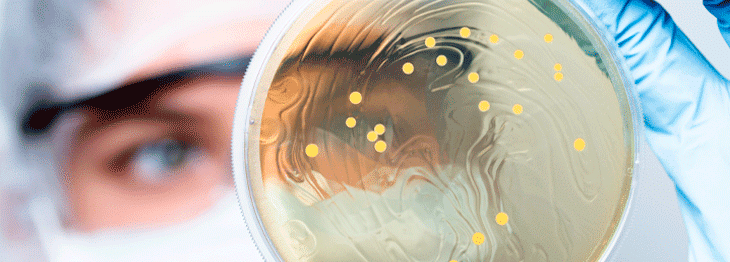

O encurtamento do período gestacional, pode ocasionar desfechos negativos materno-infantis. Vamos conversar sobre isso? Vem comigo!

Um estudo de coorte avaliou 33 pacientes com obesidade e diabetes mellitus, para mensurar a eficácia de tratamentos para perda de peso. Saiba mais

Apesar de ainda enfrentarmos a pandemia, esta é a dúvida que surge em profissionais de saúde e população em geral. Entenda as características da doença.

O Escore Apgar, conhecido pela sua simplicidade e confiabilidade, é um dos métodos mais utilizados para avaliação imediata do recém-nascido.
Estudo mostra que probióticos previnem a recorrência de vaginose bacteriana, causada pelo desequilíbrio da flora vaginal, proliferando bactérias anaeróbias.

Novos estudos sugerem que suplementação de Vitamina D pode reduzir risco de infecção e morte por COVID-19 e outras infecções respiratórias virais.